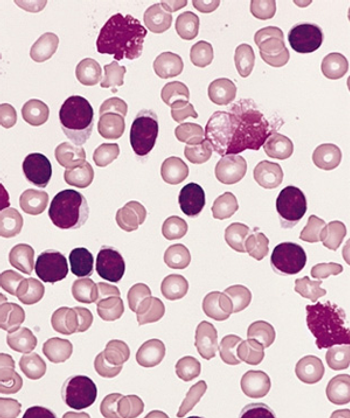

Tolerable safety and durable remissions seen with ublituximab and umbralisib plus ibrutinib for patients with chronic lymphocytic leukemia who had detectable minimal residual disease after previous ibrutinib therapy.

Your AI-Trained Oncology Knowledge Connection!


Tolerable safety and durable remissions seen with ublituximab and umbralisib plus ibrutinib for patients with chronic lymphocytic leukemia who had detectable minimal residual disease after previous ibrutinib therapy.

Improvement in major molecular response rate and depth of response coupled with a favorable safety profile were noted with asciminib vs bosutinib in patients with chronic-phase chronic myeloid leukemia.

After 3 years of follow-up in the ASCEND study, progression-free survival continues to favor acalabrutinib vs investigator’s choice of therapy for relapsed chronic lymphocytic leukemia.

Patients with chronic lymphocytic leukemia experienced improved quality of life after being treated with continuous ibrutinib and rituximab, as well as frontline fludarabine, cyclophosphamide, and rituximab.

The infusion of E-Coli- and Erwinia-derived asparaginase therapies combined with chemotherapy appeared to be well tolerated with biological efficacy in patients with acute lymphoblastic leukemia under the age of 55, providing an additional option for patients for whom further asparagine treatment is contraindicated due to toxicity.

In a population of patients with chronic myeloid leukemia with resistant disease experienced promising activity following treatment with ponatinib regardless of T315I mutation status.

Jennifer A. Woyach, MD, spoke about the phase 3 AO41202 study, which investigated different ibrutinib regimens for elderly patients with chronic lymphocytic leukemia.

High rates of undetectable minimal residual disease were found in fit patients with chronic lymphocytic leukemia who were treated with venetoclax plus either obinutuzumab or ibrutinib vs chemoimmunotherapy.

Ibrutinib and ventoclex given in the frontline setting demonstrated deeper and longer minimal residual disease for elderly and unfit patients with chronic lymphocytic leukemia.

Patients with chronic lymphocytic leukemia who were treated with ibrutinib and venetoclax in the first line continued to demonstrate deep, durable responses with new data showing further benefit to continuous ibrutinib therapy after 2 years.

The combination of MRD-guided ibrutinib and venetoclax demonstrated feasibility for treating patients with relapsed/refractory chronic lymphocytic leukemia.

The leukemia expert talks about how current findings may hold promise for a larger group of patients in the future.

IDH1/2 mutations have been detected in nearly 20% of patients with acute myeloid leukemia.

Short expanded on the future of acute lymphoblastic leukemia and transplantation necessity at the 2020 ASH Annual Meeting & Exposition.

Pollyea discussed the rationale behind a study of venetoclax and azacitidine for patients with acute myeloid leukemia with IDH mutations

Data from initial dose cohorts of a phase 1/2 trial indicated the agent was found to safely drive natural killer cell proliferation in patients with high-risk myelodysplastic syndromes and acute myeloid leukemia.

A phase 2 trial found that SY-1425 and azacitidine demonstrated clinical activity with acceptable tolerability in a heavily pretreated population of patients with relapsed/refractory acute myeloid leukemia with RARA positivity.

In preliminary findings from the ongoing first-in-human KOMET-001 trial, KO-539 showed activity in patients with relapsed or refractory acute myeloid leukemia.

An integrated analysis of 2 phase 3 studies with up to 6.5 years of follow-up reported the outcomes of first-line ibrutinib (Imbruvica) in patients with chronic lymphocytic leukemia and small lymphocytic lymphoma and high-risk genomic features.

This pooled analysis from 4 clinical trials suggested that though patients with TP53 aberrations remain at risk for progression, first-line treatment with ibrutinib has meaningfully improved the poor prognosis in this high-risk population.

Census tract socioeconomic status information demonstrated significant disparities between survival outcomes of non-Hispanic white, non-Hispanic black, and Hispanic patients with acute myeloid leukemia AML in the Chicago metropolitan area.

Azacitidine, was shown to significantly prolong overall survival and relapse-free survival in patients with acute myeloid leukemia in first remission regardless of the number of rounds of prior consolidation therapy.

Following a fixed-treatment duration of ibrutinib combined with venetoclax achieved similar 1-year disease-free survival in patients with previously untreated chronic lymphocytic leukemia/small lymphocytic lymphoma.

Treatment with the combination regimen improved progression-free survival (PFS) and overall survival (OS) over a 5-year period compared with patients treated with bendamustine and rituximab.

Naval Daver, MD, explains the progress made on 3 abstracts he’s involved with regarding acute myeloid leukemia (AML) at the ASH Annual Meeting and Exposition.

Courtney DiNardo, MD, MSCE, elaborated on interim phase II results regarding enasibenib plus azacitidine in patients with newly diagnosed acute myeloid leukemia, and the results from the QUAZAR trial.

The combination of ibrutinib and rituximab demonstrated superior progression-free survival in older patients with previously untreated chronic lymphocytic leukemia.
The triplet regimen consisting of acalabrutinib, venetoclax, and obinutuzumab appeared highly active as frontline therapy for patients with chronic lymphocytic leukemia.

Acalabrutinib alone and in combination with obinutuzumab significantly improved progression-free survival, compared with obinutuzumab plus chlorambucil in treatment-naïve patients with chronic lymphocytic leukemia

First-line treatment with ibrutinib plus venetoclax provided high rates of undetectable minimal residual disease in peripheral blood and bone marrow of patients with chronic lymphocytic leukemia.